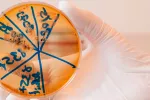

El ictus acaba con las neuronas por ondas eléctricas, no por toxicidad

08/03/2022
Los accidentes cerebrovasculares son la segunda causa de muerte en el mundo y la primera causa de discapacidad, explica Oscar Herrera, investigador del Consejo Superior de Investigaciones Científicas (CSIC). Este investigador, junto con otros especialistas, han descubierto que los ictus cerebrales acaban con las neuronas por ondas eléctricas letales, y no por toxicidad química como se pensaba hasta ahora.
Cuando se produce una interrupción en el torrente sanguíneo cerebral, se crea una onda de potencial eléctrico que viaja por los tejidos apagando las neuronas que encuentra a su paso, por lo que dejan de generar electricidad y de procesar la información, expone el estudio, publicado en la revista Neurocritical Care.
Herrera hace hincapié en que las neuronas son las células más sensibles a la carencia de glucosa y oxígeno, por lo que tan solo unos pocos minutos sin riesgo sanguíneo que transportan esos dos elementos y mueren. Ahora han encontrado que antes de esto se produce una onda eléctrica, que junto a la falta de oxígeno y glucosa, lleva a una entrada masiva de agua al interior, del que las neuronas no se pueden recuperar.
Unas ondas también observadas en las migrañas
“Han sido tres décadas de experimentación dedicada a probar una y otra vez que las neuronas mueren cuando son sometidas a un ambiente tóxico por exceso de glutamato (teoría excito-tóxica), una molécula neurotransmisora que se derrama desde las células en gran cantidad en ausencia de oxígeno y resulta letal para sus vecinas. Pero este no es el primer ni el principal evento que ocurre tras un accidente cerebrovascular”, explica Oscar Herrera.
Estas ondas eléctricas también se han encontrado en las fases de aura de las migrañas, pero en ellas solo duran un minuto y el tejido nervioso se recupera pronto
Llama la atención que esta onda de potencial eléctrico también se ha encontrado en la fase de aura de las migrañas. Sin embargo, en estos casos solo dura un minuto y el tejido nervioso se logra recuperar completamente. Este descubrimiento podría ayudar a establecer estas ondas como diana terapéutica.
“Podemos revertir esta situación de impasse clínico si dotamos a las UCI de equipo para registrar estas ondas en los pacientes y empezamos a diseñar estrategias para detenerlas. Algunas ya se están probando en laboratorio. Esperamos que esta publicación sea el primer paso para reorientar la investigación de una manera radical y comenzar a diseñar estrategias que, por fin, puedan ser útiles a los pacientes con accidente cerebrovascular”, señala el investigador.
Por ello, instan a que se preste más atención a estas ondas eléctricas en los pacientes de las UCI con hemorragias cerebrales, ictus o con traumatismos craneales, pues su presencia y duración son las mejores formas de conocer la gravedad del daño causado y del tejido nervioso que ha sido dañado y que no se podrá recuperar.
Actualizado: 5 de mayo de 2023